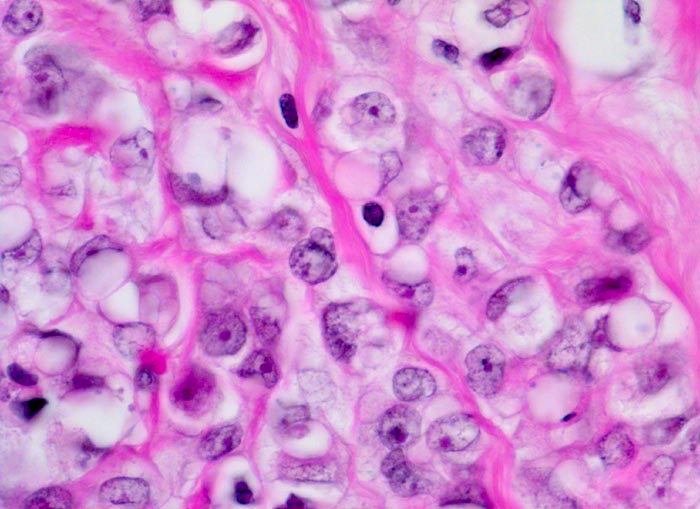

PathoPic – image database / PathoPic ID 4224 - invasiv lobuläres Karzinom : Siegelringzellen
de
Diagnose
invasiv lobuläres Karzinom : Siegelringzellen
Diagnose Gruppe
maligner Tumor
Topographie
Mamma
Topographie Gruppe
Mamma
Beschreibung
Zu Strängen angeordnete Tumorzellen mit intrazytoplasmatischen Vakuolen, welche den Kern zur Seite drängen (Siegelringzellen)
Bilder Typ
Histologie
Vergrösserung
630
Alter
57
Geschlecht
unbekannt
Datum
Ersteintrag: 05.03.2002
Update: 04.02.2024